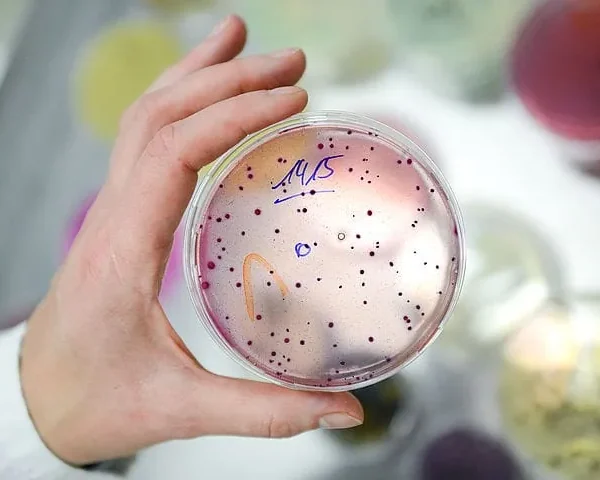
Procedura autocontrol restaurant

- HACCP LABORATOR COFETARIE, LABORATOARE PATISERIE-COFETARIE
HACCP-PROGRAM AUTOCONTROL LABORATOARE COFETARIE
- Materialele se livreaza în format editabil astfel încât pot fi adaptate la nivelul unității dumneavoastra! Descarcarea materialelor se face direct din site, imediat dupa efectuarea platii! Operatorii economici care doresc informatii suplimentare si consultanta la unitate, pot solicita la numarul de telefon: 0784 575 621 sau pe email la haccp.siguranta@yahoo.com.
- Citește mai mult
- RESTAURANTE
Managementul deseurilor de restaurante
- Materialele se livreaza în format editabil astfel încât pot fi adaptate la nivelul unității dumneavoastra! Descarcarea materialelor se face direct din site, imediat dupa efectuarea platii! Operatorii economici care doresc informatii suplimentare si consultanta la unitate, pot solicita la numarul de telefon: 0784 575 621 sau pe email la haccp.siguranta@yahoo.com.
- Citește mai mult
- RESTAURANTE
Procedura autocontrol restaurant
- Materialele se livreaza în format editabil astfel încât pot fi adaptate la nivelul unității dumneavoastra! Descarcarea materialelor se face direct din site, imediat dupa efectuarea platii! Operatorii economici care doresc informatii suplimentare si consultanta la unitate, pot solicita la numarul de telefon: 0784 575 621 sau pe email la haccp.siguranta@yahoo.com.
- Citește mai mult
- HACCP LABORATOR COFETARIE, LABORATOARE PATISERIE-COFETARIE
PROCEDURA HACCP DESEURI LABORATOR COFETARIE
- Materialele se livreaza în format editabil astfel încât pot fi adaptate la nivelul unității dumneavoastra! Descarcarea materialelor se face direct din site, imediat dupa efectuarea platii! Operatorii economici care doresc informatii suplimentare si consultanta la unitate, pot solicita la numarul de telefon: 0784 575 621 sau pe email la haccp.siguranta@yahoo.com.
- Citește mai mult
- BRUTARIE
PROCEDURA HACCP IGIENIZARE SPATII BRUTARIE
- Materialele se livreaza în format editabil astfel încât pot fi adaptate la nivelul unității dumneavoastra! Descarcarea materialelor se face direct din site, imediat dupa efectuarea platii! Operatorii economici care doresc informatii suplimentare si consultanta la unitate, pot solicita la numarul de telefon: 0784 575 621 sau pe email la haccp.siguranta@yahoo.com.
- Citește mai mult
- Fără categorie
PROCEDURĂ IGIENA PERSONALULUI ȘI CONTROLUL STĂRII DE SĂNĂTATE
- Materialele se livreaza în format editabil astfel încât pot fi adaptate la nivelul unității dumneavoastra! Operatorii economici care doresc personalizarea procedurilor pot solicita informatii suplimentare si consultanta la numarul de telefon: 0784 575 621 sau pe email la haccp.siguranta@yahoo.com
- Citește mai mult
- DEPOZITE NON-ANIMAL
PROCEDURA IGIENIZARE DEPOZITE ALIMENTARE NON-ANIMAL
- Materialele se livreaza în format editabil astfel încât pot fi adaptate la nivelul unității dumneavoastra! Descarcarea materialelor se face direct din site, imediat dupa efectuarea platii! Operatorii economici care doresc informatii suplimentare si consultanta la unitate, pot solicita la numarul de telefon: 0784 575 621 sau pe email la haccp.siguranta@yahoo.com.
- Citește mai mult
- FURAJE
PROCEDURA IGIENIZARE DEPOZITE FURAJE PENTRU ANIMALE
- Materialele se livreaza în format editabil astfel încât pot fi adaptate la nivelul unității dumneavoastra! Descarcarea materialelor se face direct din site, imediat dupa efectuarea platii! Operatorii economici care doresc informatii suplimentare si consultanta la unitate, pot solicita la numarul de telefon: 0784 575 621 sau pe email la haccp.siguranta@yahoo.com.
- Citește mai mult
- RESTAURANTE
PROCEDURA IGIENIZARE UTILAJE SI USTENSILE DE LUCRU RESTAURANTE
- Materialele se livreaza în format editabil astfel încât pot fi adaptate la nivelul unității dumneavoastra! Descarcarea materialelor se face direct din site, imediat dupa efectuarea platii! Operatorii economici care doresc informatii suplimentare si consultanta la unitate, pot solicita la numarul de telefon: 0784 575 621 sau pe email la haccp.siguranta@yahoo.com.
- Citește mai mult
- Fără categorie
PROCEDURA IGIENIZAREA SPAȚIILOR ȘI ECHIPAMENTELOR DE DE LUCRU
- Materialele se livreaza în format editabil astfel încât pot fi adaptate la nivelul unității dumneavoastra! Descarcarea materialelor se face direct din site, imediat dupa efectuarea platii! Operatorii economici care doresc informatii suplimentare si consultanta la unitate, pot solicita la numarul de telefon: 0784 575 621 sau pe email la haccp.siguranta@yahoo.com.
- Citește mai mult
- CATERING, LABORATOARE PATISERIE-COFETARIE, RESTAURANTE
PROCEDURA PRIVIND INSTRUIRE PERSONAL ANGAJAT IN SECTORUL ALIMENTAR
- Materialele se livreaza în format editabil astfel încât pot fi adaptate la nivelul unității dumneavoastra! Descarcarea materialelor se face direct din site, imediat dupa efectuarea platii! Operatorii economici care doresc informatii suplimentare si consultanta la unitate, pot solicita la numarul de telefon: 0784 575 621 sau pe email la haccp.siguranta@yahoo.com.
- Citește mai mult
- DEPOZITE NON-ANIMAL
Procedura retragere/rechemare produse alimentare in unitati depozitare
- Materialele se livreaza în format editabil astfel încât pot fi adaptate la nivelul unității dumneavoastra! Descarcarea materialelor se face direct din site, imediat dupa efectuarea platii! Operatorii economici care doresc informatii suplimentare si consultanta la unitate, pot solicita la numarul de telefon: 0784 575 621 sau pe email la haccp.siguranta@yahoo.com.
- Citește mai mult